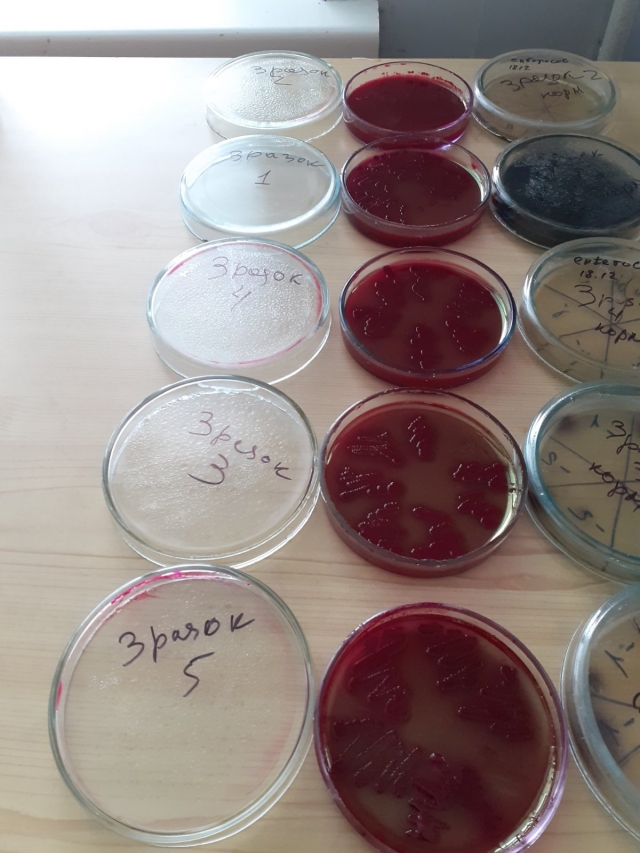
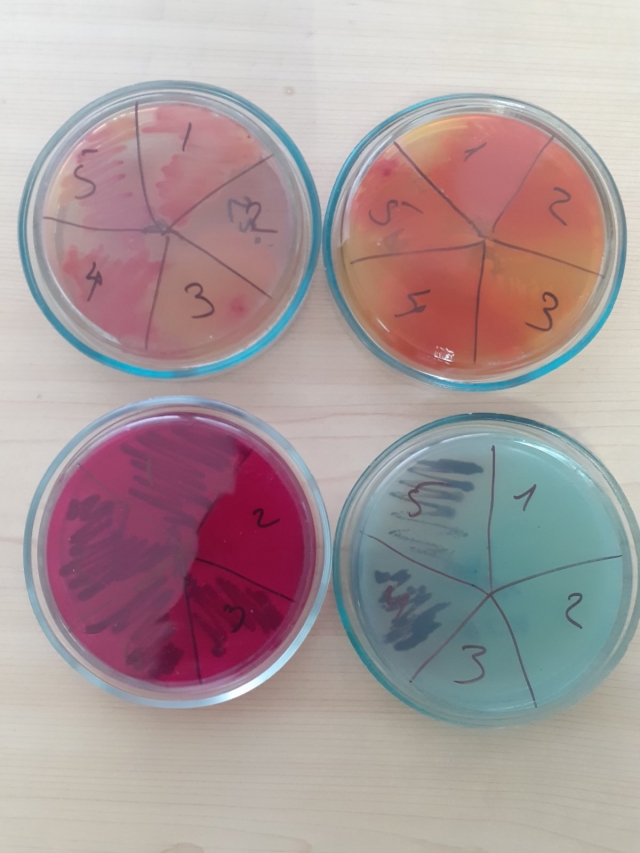
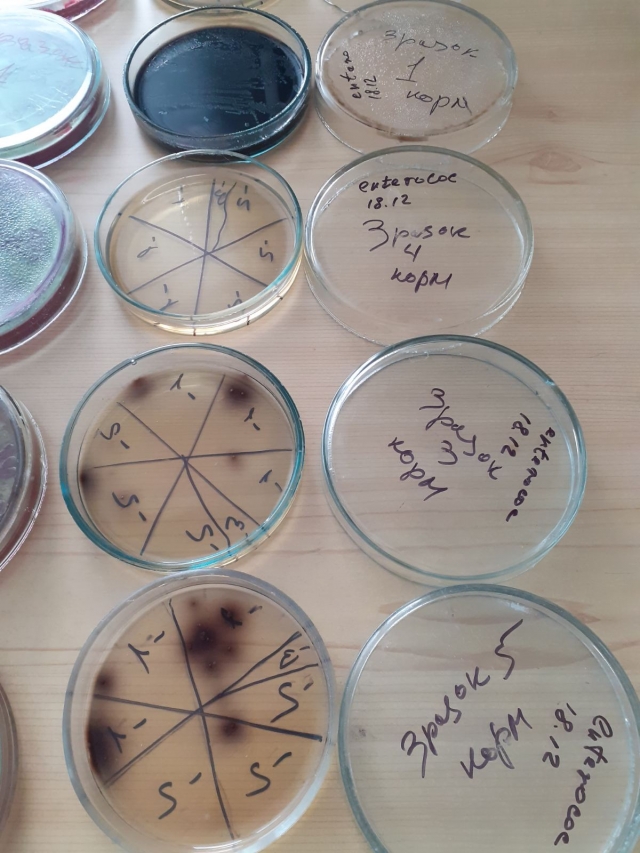

Наукова діяльність кафедри епізоотології, мікробіології і вірусології
Не дивлячись, на те, що на разі затишшя в студентських аудиторіях, робота на кафедрі епізоотології, мікробіології і вірусології не припиняється ні на хвилину. Співробітники кафедри активно займаються методичною роботою та підготовкою матеріалів для проведення лекційних і практичних занять з дисциплін кафедри.

Окрім того активно проводиться і наукова діяльність на кафедрі. Наразі професори Валерій Ушкалов, Лілія Виговська, асистент Олексій Шевченко, лікар ветеринарної медицини Тетяна Марковська та препаратор Дарина Шевченко, зайняті в проведенні ряду наукових досліджень (виконання теми №110/4-пр-2023, «Конструювання засобів діагностики збудників актуальних ендемічних зоонозів з високим генетичним та фенотиповим потенціалом патогенності» (керівник професор Виговська Л.М.), що спрямовані на дослідження якості та безпеки кормів за мікробіологічними показниками для продуктивних тварин (велика рогата худоба), а саме:
- визначення чисельності дріжджів і пліснявих грибів;
- виявлення найбільш вірогідного числа бактерій родини Enterobacteriaceae, Enterococcus Spp., сульфітредукуючих клостридій (Clostridium perfringens);
- виявлення наявності патогенних мікроорганізмів: Salmonella spp., Escherichia coli, Yersinia enterocolitica, Listeria monocytogenes.

Науковці кафедри здійснюють мікробіологічні дослідження продуктів харчування та сировини на відповідність вимогам нормативно-технічної документації, щодо показників якості та безпеки.
Для роботи використовуються нові сучасні міжнародні та вітчизняні методики, ДСТУ тощо.

Дослідження проводяться на високому сучасному рівні з використанням сучасного обладнання, комерційних стандартизованих поживних середовищ, біохімічних тестових наборів для ідентифікації, тест-систем для експрес діагностики. Особлива увага приділяється забезпеченню якості і достовірності мікробіологічних досліджень.
Володимир Мельник, зав каф. епізоотології,
мікробіології і вірусології